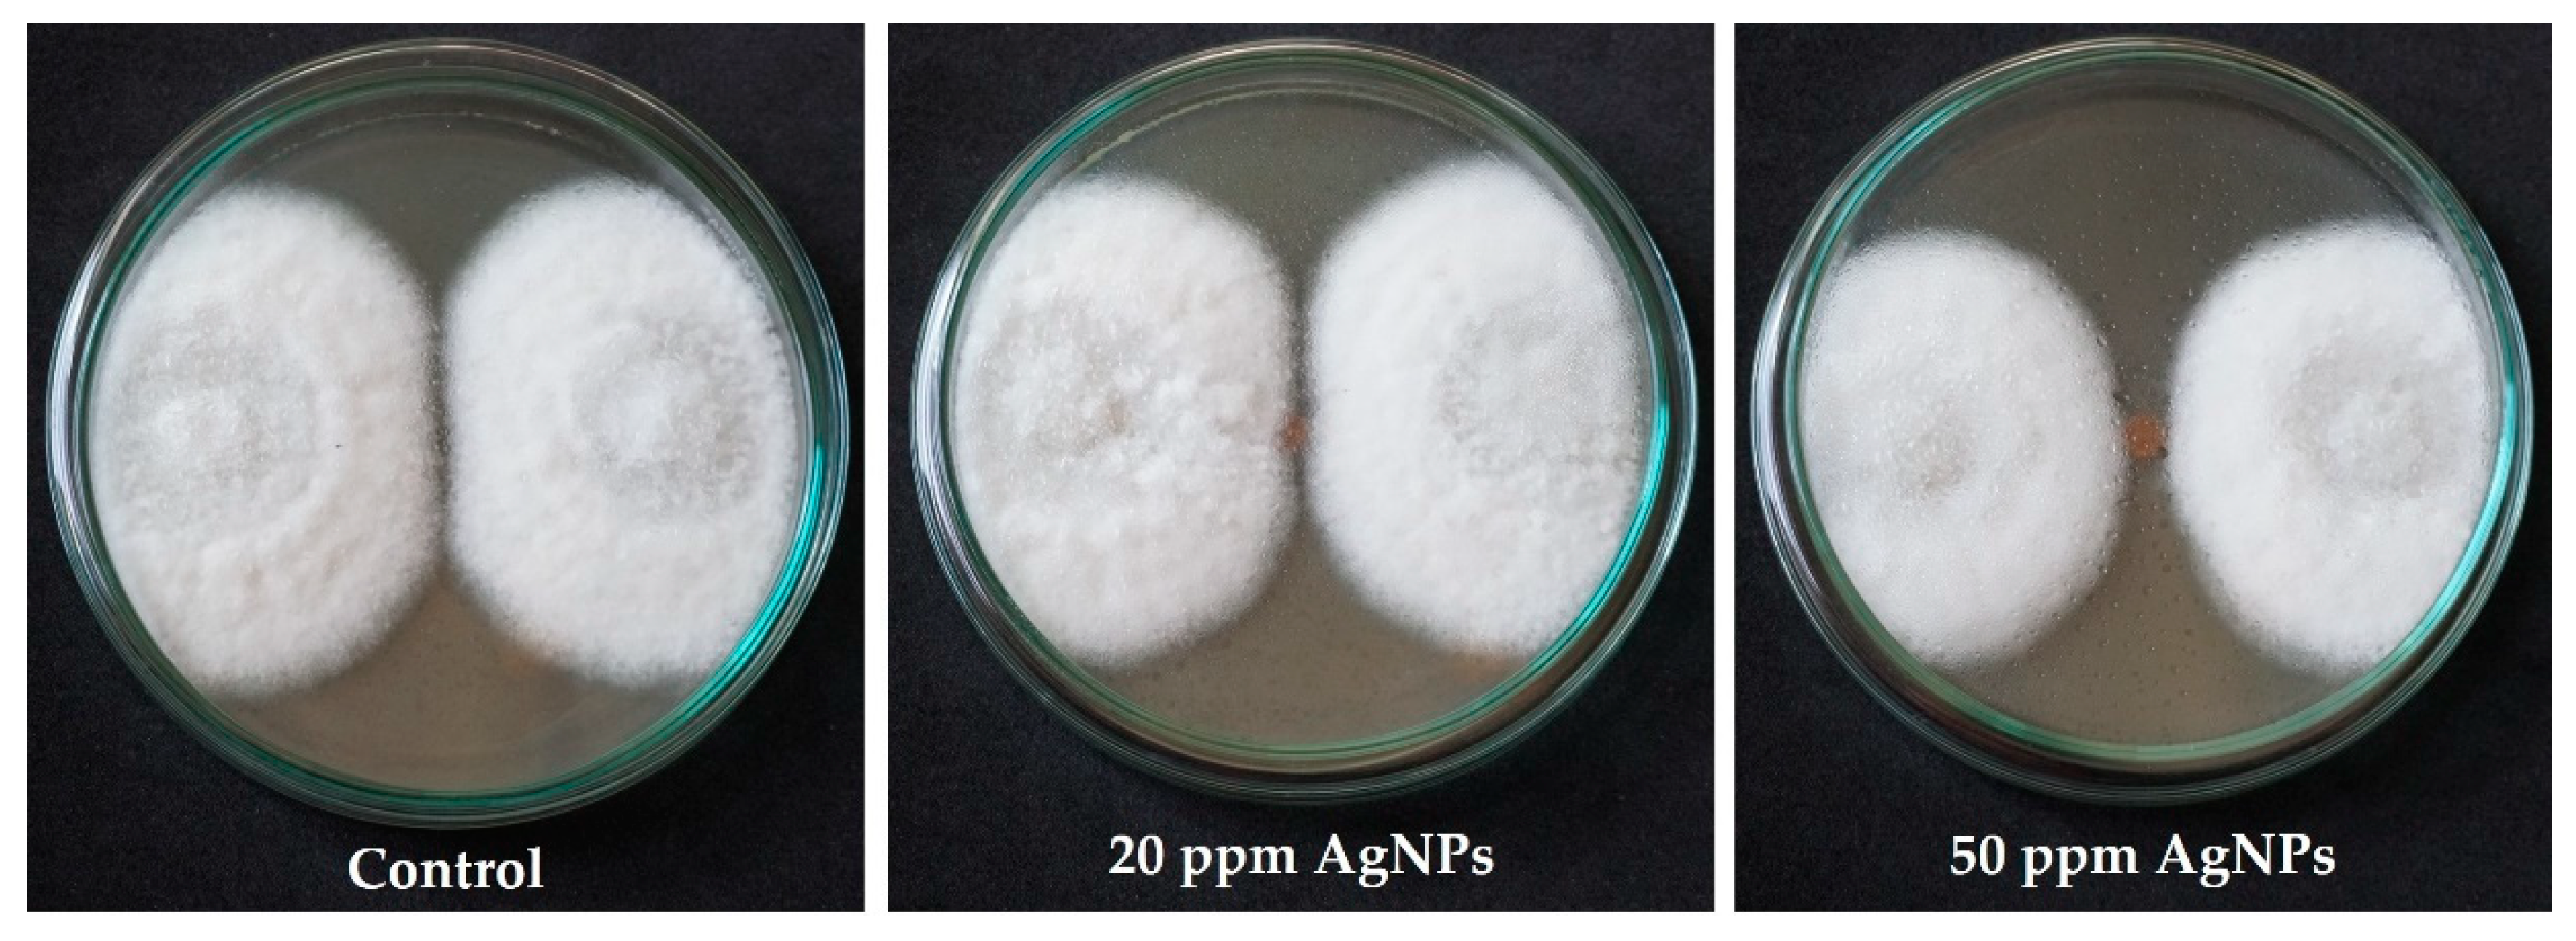

Silver Nanoparticle-Based Paper Packaging to Combat Black Anther Disease in Orchid Flowers
Abstract
1. Introduction
2. Materials and Methods
2.1. Materials
2.2. Synthesis of Silver Nanoparticles
2.3. Preparation of Antifungal Coating Solution
2.4. Preparations of Antifungal Coating Papers
2.5. Antifungal Activity of the Coated Paper
2.6. Basis Weight and Thickness
2.7. Tensile and Bursting Test
2.8. Water Absorptiveness
2.9. Antifungal Activity of the Coated Paper
2.10. Statistical Analysis
3. Results
3.1. Synthesis of AgNPs
3.2. Antifungal Activity of Coated Paper
3.3. Morphology of Uncoated and Coated Paper
3.4. Basis Weight and Thickness
3.5. Tensile and Burst Strength
3.6. Water Absorptiveness
3.7. Effect of AgNP Coating on C. Gloeosporioides
4. Conclusions
Author Contributions
Funding
Acknowledgments
Conflicts of Interest
References
- Chowdappa, P.; Chethana, C.S.; Bharghavi, R.; Sandhya, H.; Pant, R.P. Morphological and molecular characterization of Colletotrichum gloeosporioides (Penz) Sac. isolates causing anthracnose of orchids in India. Biotechnol. Bioinf. Bioeng. 2012, 2, 567–572. [Google Scholar]
- Office of Agricultural Economic. Exporting Value of Orchid Cut Flower in Thailand on 2015–2017. Available online: http://oldweb.oae.go.th/production.html (accessed on 11 January 2019).
- Thammasiri, K. Thai orchid genetic resources and their improvement. Horticulturae 2016, 2, 9. [Google Scholar] [CrossRef]
- Wittayawannakul, W.; Tassakorn, T.; Bhasabutra, T. Postharvest control of black anther disease in dendrobium. Agric. Sci. J. 2012, 43, 584–587. [Google Scholar]
- Tassakorn, T.; Bhasabutra, T.; Wittayawannakul, W. Chemical Control of Black Anther Disease on Dendrobium Orchids. Available online: http://www.doa.go.th/research/showthread.php?tid=1781 (accessed on 11 March 2018).
- Chowdappa, P.; Gowda, S.; Chethana, C.S.; Madhura, S. Antifungal activity of chitosan-silver nanoparticle composite against Colletotrichum gloeosporioides associated with mango anthracnose. Afr. J. Microbiol. Res. 2014, 8, 1803–1812. [Google Scholar]
- Junqueira-Gonçalves, M.P.; Alarcón, E.; Niranjan, K. Development of antifungal packaging for berries extruded from recycled PET. Food Control 2013, 33, 455–460. [Google Scholar] [CrossRef]
- Rudra, S.G.; Singh, V.; Jyoti, S.D.; Shivhare, U.S. Mechanical properties and antimicrobial efficacy of active wrapping paper for primary packaging of fruits. Food Biosci. 2013, 3, 49–58. [Google Scholar] [CrossRef]
- Lamsal, K.; Kim, S.W.; Jung, J.H.; Kim, Y.S.; Kim, K.S.; Lee, Y.S. Application of silver nanoparticles for the control of Colletotrichum species in vitro and pepper anthracnose disease in field. Mycobiology 2011, 39, 194–199. [Google Scholar] [CrossRef] [PubMed]
- Aguilar-Méndez, M.A.; Martín-Martínez, E.S.; Ortega-Arroyo, L.; Cobián-Portillo, G.; Sánchez-Espíndola, E. Synthesis and characterization of silver nanoparticles: Effect on phytopathogen Colletotrichum gloesporioides. J. Nanoparticle Res. 2013, 13, 2525–2532. [Google Scholar] [CrossRef]
- Nokkrut, B.; Pisutpiched, S.; Puangsin, B. Effect of quaternary ammonium compounds and zinc pyrithione on antimicrobial properties in packaging containers for orchid cut flowers. Thai J. For. 2017, 36, 136–144. [Google Scholar]
- Chaichompoo, W.; Phichai, K. Effect of plant extract on growth inhibition of Colletotrichum sp. Res. J. 2010, 3, 18–25. [Google Scholar]
- Kang, H.C.; Park, Y.H.; Go, S.J. Growth inhibition of a phytopathogenic fungus, Colletotrichum species by acetic acid. Microbiol. Res. 2003, 158, 321–326. [Google Scholar] [CrossRef] [PubMed]
- Shi, X.; Li, B.; Qin, G.; Tian, S. Mechanism of antifungal action of borate against Colletotrichum gloeosporioides related to mitochondrial degradation in spores. Postharvest Biol. Technol. 2012, 67, 138–143. [Google Scholar] [CrossRef]
- Bussaman, P.; Namsena, P.; Rattanasena, P.; Chandrapatya, A. Effect of crude leaf extracts on Colletotrichum gloeosporioides (Penz.) Sacc. Psyche A J. Entomol 2012, 1, 309046. [Google Scholar]
- Echegoyen, Y.; Nerín, C. Nanoparticle release from nano-silver antimicrobial food containers. Food Chem. Toxicol. 2013, 62, 16–22. [Google Scholar] [CrossRef]
- Carbone, M.; Donia, D.T.; Sabbatella, G.; Antiochia, R. Silver nanoparticles in polymeric matrices for fresh food packaging. J. King Saud Univ. Sci. 2016, 28, 273–279. [Google Scholar] [CrossRef]
- Agnihotri, S.; Mukherji, S.; Mukherji, S. Size-controlled silver nanoparticles synthesized over the range 5–100 nm using the same protocol and their antibacterial efficacy. RSC Adv. 2014, 4, 3974–3983. [Google Scholar] [CrossRef]
- ISO 536 Paper and Board-Determination of Grammage; International Organization for Standardization: Geneva, Switzerland, 1995.
- ISO 534 Paper and Board-Determination of Thickness, Density and Specific Volume; International Organization for Standardization: Geneva, Switzerland, 2005.
- ISO 1924-2 Paper and Board-Determination of Tensile Properties Part 2 Constant Rate of Elongation Method; International Organization for Standardization: Geneva, Switzerland, 2008.
- ISO 2758 Paper Determination of Bursting Strength; International Organization for Standardization: Geneva, Switzerland, 2001.
- ISO 535 Paper and Board-Determination of Water Absorptiveness-Cobb Method; International Organization for Standardization: Geneva, Switzerland, 1991.
- Pacioni, N.L.; Borsarelli, C.D.; Rey, V.; Veglia, A.V. Synthetic routes for the preparation of silver nanoparticles. In Silver Nanoparticle Applications; Alarcon, E.I., Griffith, M., Udekwu, K.I., Eds.; Springer International Publishing: Basel, Switzerland, 2015; Volume 1, pp. 13–45. [Google Scholar]
- Paramelle, D.; Sadovoy, A.; Gorelik, S.; Free, P.; Hobley, J.; Fernig, D.G. Rapid method to estimate the concentration of citrate capped silver nanoparticles from UV-visible light spectra. Analyst 2014, 139, 4855–4861. [Google Scholar] [CrossRef]
- Tomaszewska, E.; Soliwoda, K.; Kadziola, K.; Tkacz-Szczesna, B.; Celichowski, G.; Cichomski, M.; Szmaja, W.; Grobelny, J. Detection limits of DLS and UV-Vis spectroscopy in characterization of polydisperse nanoparticles colloids. J. Nanomater. 2013, 60. [Google Scholar] [CrossRef]
- Li, Y.; Zhang, J.; Li, H.; Gu, W.J.; He, B. Analysis of the coating surface properties of coated paper. In Proceedings of the 2015 International Conference on Materials, Environmental and Biological Engineering (MEBE 2015), Guilin, China, 28–30 March 2015; pp. 250–253. [Google Scholar]
- Amini, E.; Azadfallah, M.; Layeghi, M.; Talaei-Hassanloui, R. Silver-nanoparticle-impregnated cellulose nanofiber coating for packaging paper. Cellulose 2016, 23, 557–570. [Google Scholar] [CrossRef]
- Bruun, S.E. Starch. In Pigment Coating and Surface Sizing of Surface; Lehtnen, E., Suomen Paperi-insinöörien Yhdistys, Technical Association of the Pulp and Paper Industry, Eds.; Fapet Oy: Jyväskylä, Finland, 2000; Volume 1, pp. 241–249. [Google Scholar]
- Butinaree, S.; Jinkarn, T.; Yoksan, R. Effects of biodegradable coating on barrier properties of paperboard food packaging. J. Met. Mater. Miner. 2008, 18, 219–222. [Google Scholar]
- Biricik, Y.; Sonmez, S.; Ozden, O. Effects of surface sizing with starch on physical strength properties of paper. Asian J. Chem. 2011, 23, 3151–3154. [Google Scholar]

| Treatment | Packaging | Pulsing Solution |
|---|---|---|
| T0 | Uncoated | Distilled water |
| T1 | Uncoated | 8-HQS 225 ppm + AgNO3 30 ppm + Sucrose 4% |
| T2 | Uncoated | 8-HQS 225 ppm + AgNPs 20 ppm + Sucrose 4% |
| T3 | AgNPs coated | 8-HQS 225 ppm + AgNO3 30 ppm + Sucrose 4% |
| T4 | AgNPs coated | 8-HQS 225 ppm + AgNPs 20 ppm + Sucrose 4% |
| Days | Inhibition (%Relative to Control) | |
|---|---|---|
| AgNPs Coated Paper (ppm) | ||
| 20 | 50 | |
| 1 | ND | ND |
| 2 | 12.00 ± 2.70 a | 36.00 ± 2.18 b |
| 3 | 3.92 ± 1.79 a | 18.95 ± 2.73 b |
| 4 | 4.88 ± 2.44 a | 11.22 ± 2.99 b |
| 5 | 4.26 ± 1.73 a | 10.08 ± 2.21 b |
| 6 | 2.72 ± 1.42 a | 6.80 ± 3.27 b |
| 7 | 0.00 ± 0.00 a | 3.33 ± 1.83 b |
| Properties | Paper | |
|---|---|---|
| Uncoated | Coated | |
| Basis weight (g/m2) | 133.88 ± 1.25 a | 137.61 ± 1.34 b |
| Thickness (µm) | 174.28 ± 0.95 a | 180.00 ± 0.72 b |
| Coating weight (g/m2) | ND | 3.73 ± 0.32 |
| Coating thickness (µm) | ND | 5.72 ± 1.15 |
| Properties | Paper | |
|---|---|---|
| Uncoated | Coated | |
| Tensile index (Nm/g) | – | – |
| MD | 56.33 ± 2.33 a | 56.02 ± 3.56 a |
| CD | 23.74 ± 1.02 a | 25.94 ± 0.98 b |
| Bursting index (kPa·m2/g) | 2.79 ±0.13 a | 3.08 ± 0.08 b |
| Treatments | Packaging | Pulsing Solution | Infection 1 (%) |
|---|---|---|---|
| T0 | Uncoated | Distilled | 40.00 ± 0.00 a |
| T1 | Uncoated | 8-HQS 225 ppm + AgNO3 30 ppm + Sucrose 4% | 29.17 ± 1.44 a |
| T2 | Uncoated | 8-HQS 225 ppm + AgNPs 20 ppm + Sucrose 4% | 31.67 ± 3.82 a |
| T3 | AgNPs coated | 8-HQS 225 ppm + AgNO3 30 ppm + Sucrose 4% | 12.50 ± 0.00 b |
| T4 | AgNPs coated | 8-HQS 225 ppm + AgNPs 20 ppm + Sucrose 4% | 12.50 ± 0.00 b |
© 2019 by the authors. Licensee MDPI, Basel, Switzerland. This article is an open access article distributed under the terms and conditions of the Creative Commons Attribution (CC BY) license (http://creativecommons.org/licenses/by/4.0/).
Share and Cite
Nokkrut, B.-o.; Pisuttipiched, S.; Khantayanuwong, S.; Puangsin, B. Silver Nanoparticle-Based Paper Packaging to Combat Black Anther Disease in Orchid Flowers. Coatings 2019, 9, 40. https://doi.org/10.3390/coatings9010040
Nokkrut B-o, Pisuttipiched S, Khantayanuwong S, Puangsin B. Silver Nanoparticle-Based Paper Packaging to Combat Black Anther Disease in Orchid Flowers. Coatings. 2019; 9(1):40. https://doi.org/10.3390/coatings9010040
Chicago/Turabian StyleNokkrut, Bang-on, Sawitree Pisuttipiched, Somwang Khantayanuwong, and Buapan Puangsin. 2019. "Silver Nanoparticle-Based Paper Packaging to Combat Black Anther Disease in Orchid Flowers" Coatings 9, no. 1: 40. https://doi.org/10.3390/coatings9010040
APA StyleNokkrut, B.-o., Pisuttipiched, S., Khantayanuwong, S., & Puangsin, B. (2019). Silver Nanoparticle-Based Paper Packaging to Combat Black Anther Disease in Orchid Flowers. Coatings, 9(1), 40. https://doi.org/10.3390/coatings9010040

